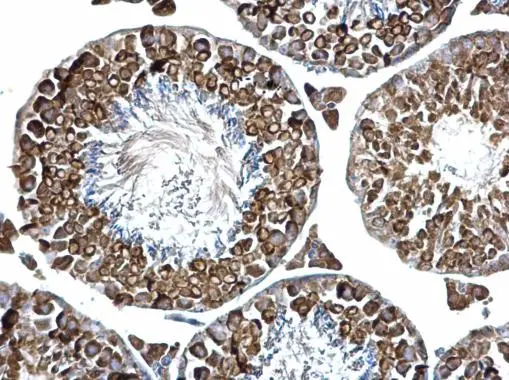
PABP antibody detects PABP protein at cytosol on mouse testis by immunohistochemical analysis. Sample: Paraffin-embedded mouse testis. PABP antibody (GTX113954) dilution: 1:500. 
 Antigen Retrieval: Trilogy? (EDTA based, pH 8.0) buffer, 15min

Immunohistochemistry of paraffin-embedded Rat testis using Polyclonal AntibodyPC1 Polyclonal Antibody at dilution of 1:100 (40x lens).
PABPC1 Polyclonal Antibody
E-AB-65139
Product group Antibodies
Overview
- SupplierElabscience
- Product NamePABPC1 Polyclonal Antibody
- Delivery Days Customer12
- CertificationResearch Use Only
- Scientific DescriptionThis gene encodes a poly(A) binding protein. The protein shuttles between the nucleus and cytoplasm and binds to the 3 poly(A) tail of eukaryotic messenger RNAs via RNA-recognition motifs. The binding of this protein to poly(A) promotes ribosome recruitment and translation initiation; it is also required for poly(A) shortening which is the first step in mRNA decay. The gene is part of a small gene family including three protein-coding genes and several pseudogenes.
- UNSPSC12352203